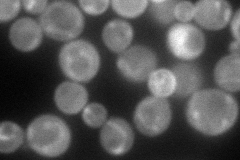
YJL145W
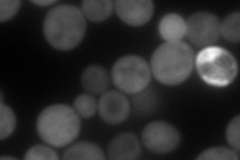
YJL145W
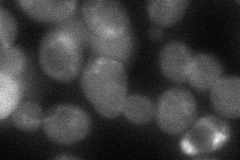
YJL145W
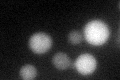
YJL145W
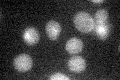
YJL145W

View description
Non-classical phosphatidylinositol transfer protein (PITP); exhibits PI- but not PC-transfer activity; localizes to the peripheral endoplasmic reticulum, cytosol and microsomes; similar to Sec14p
Localization:
Intensity:
Fold change:
Significance:
-
C’ GFP library in SD

cytosol31.38 -
N' NOP1pr-GFP in SD
cell periphery,punctate126.522 -
N' TEF2pr-mCherry in SD
cytosol,bud neck218.611 -
N' NATIVEpr-GFP in SD

punctate,mitochondria54.8233 -
N' TEF2pr-VC and Cyto-VN in SD
cytosol51.9537 -
C’ GFP library in SD+DTT
cytosol31.981.01No -
C’ GFP library in SD+H2O2

cytosol35.511.13No -
C’ GFP library in Starvation Media
cytosol24.020.76No -
C’ GFP library on the background of Pup2-DaMP

cytosol -
C’ GFP library on the background of CCT mutant

cytosol30.22160.962953No
